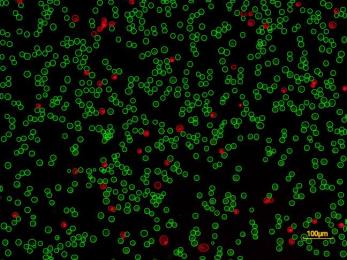
新闻图片11

翌圣生物科技(上海)股份有限公司品牌商
19 年
手机商铺
- NaN
- 0.7999999999999998
- 1.7999999999999998
- 0.7999999999999998
- 3.8
翌圣生物科技(上海)股份有限公司
入驻年限:19 年
- 联系人:
翌圣生物
- 所在地区:
上海
- 业务范围:
体外诊断、耗材、技术服务、抗体、ELISA 试剂盒、细胞库 / 细胞培养、试剂
- 经营模式:
生产厂商
推荐产品
公司新闻/正文
带你认识伴刀豆球蛋白A磁珠
738 人阅读发布时间:2024-07-23 09:35
本文介绍伴刀豆球蛋白A,及其与磁珠共价偶联后的ConA磁珠的应用场景。
伴刀豆球蛋白A磁珠 (Concanavalin A-Coated Magnetic Beads,简称ConA磁珠),顾名思义,就是植物凝集素伴刀豆球蛋白A(ConA)和超顺磁性纳米材料进行偶联的一种生物磁珠。下面将逐一介绍有关ConA磁珠的那些事儿。
伴刀豆球蛋白A(Concanavalin A, ConA),是自1936年以来,第一个从刀豆(Canavalia ensiformis,洋刀豆)分离纯化结晶的一种植物凝集素蛋白,无血型特异性。
ConA根据所处溶液pH值的不同,主要有2种形式:α-2 同源二聚体或 α-4 同源四聚体[2]。碱性条件下(pH>7.0)以四聚体(四个分子量为26kDa亚基构成)形式存在;酸性条件(pH 4.5-5.5)下,Con A解离为活化的二聚体结构(52kDa)。除此之外,ConA的功能受二价阳离子的影响,如在缺乏金属离子(Ca2+ 和 Mn2+ )的情况下,其构象、糖蛋白结合功能是无法得到发挥[1]。

图1.ConA分子模型(A) ConA monomer, (B) ConA dimer, (C) ConA tetramer with mannose, glucose and metal ions
生物磁珠是一类具有纳米粒径大小,由高分子聚合物和无机磁性纳米粒子形成的磁性微球。磁珠按照其结构可以分为三大类:核-壳型结构、夹层式结构、弥散型结构。磁性物质有纯铁粉、磁性矿、正铁酸盐、铁钴合金等。
磁性纳米材料,因其具备特殊的效应,如小尺寸效应、表面效应和量子尺寸效应等,在Fe3O4 纳米颗粒的尺寸小于30 nm时, 纳米颗粒内部热骚动的干扰表现显著, 此时, 这类纳米颗粒就表现出一种特殊的磁学性质, 即超顺磁性。超顺磁性Fe3O4 纳米颗粒具备优质的属性,如无毒、良好的生物相容性、独特的磁靶向特性以及在交变磁场中易于产热等性质, 在生物行业中得到广泛应用。
而将ConA与微球进行共价偶联用于固定生物分子,则有以下优势:
-
1. 共价偶联结合稳定性高,便于重复;
-
2.配体ConA结合在微珠表面,可用于靶分子相互作用;
-
3.溶液环境的动力学特征,适合生物学实验操作。
根据文献报导,ConA磁珠的主要应用分为3种场景,分别是进行细胞质膜分离、糖蛋白富集、和分离固定细胞方面。
细胞质膜分离
利用ConA磁珠受二价阳离子的激活影响,使其存在于Ca²⁺和Mg²⁺溶液环境中,其具备的末端α-D-甘露糖基和α-D-葡萄糖基的亲和作用功能,用在质膜纯化方面,是一种简便、高效的方式。如细胞或组织的质膜分离,是进一步获取质膜蛋白的关键步骤。而ConA是能结合细胞上糖基化蛋白,可利用此原理,获取纯度更高的质膜。主要操作步骤为:通过将生物素化的ConA与链霉亲和素磁珠结合,将ConA固定在磁珠上;细胞膜与ConA磁珠孵育1h;磁力架上吸附;TBS洗涤5次;洗脱液洗脱细胞质膜溶液[3]。

图2. ConA磁珠纯化质膜步骤
糖蛋白富集
ConA对甘露糖(mannose)和葡萄糖(glucose)具有特异性,且ConA识别α-连接甘露糖,这种甘露糖恰好是许多血清和细胞膜糖蛋白的“核心寡糖”。因此可用在免疫学等方面的分离细胞或组织裂解液或血清中的糖蛋白等糖基化分子。
主要操作步骤为:通过双功能连接剂亚油酸双- N-羟基琥珀酰亚胺酯 (DSS) 将( MNPs) 与ConA进行交联,获取ConA磁珠;使用甲氧基乙二醇(MEG)终止磁性纳米微球的非特异性结合,进行磁分离;将加入用胰蛋白酶消化的细胞膜蛋白提取液,与ConA磁珠两者孵育,磁力架收集已结合糖蛋白的ConA磁珠,洗涤非糖肽,最后洗脱捕获的糖肽,进行真空干燥。通过该方法,可以对肿瘤相关蛋白 (如EGFR) 的特定糖基化位点进行深入分析[4]。

图3. 超顺磁性纳米颗粒偶联不同凝集素
分离固定细胞
利用ConA磁珠(磁珠与高纯度的伴刀豆球蛋白A共价结合)与细胞膜或核膜上的糖蛋白结合,从而捕获细胞或细胞核,可实现少量细胞的实验操作可视化。如ConA磁珠用于用于研究染色质结构和功能的新型技术的CUT&Tag和CUT&RUN[5]实验中,通过ConA磁珠与细胞结合固定,实现可视化操作,避免离心带来的细胞丢失问题。
相对传统研究DNA与蛋白互作的ChIP-seq技术,CUT&Tag和CUT&RUN具备以下优势:
-
ConA磁珠与细胞膜糖蛋白结合,可视化操作,提升实验操作体验感;
-
无需离心,只需要ConA磁珠吸附在磁力架上,即可完成细胞样本和溶液的分离;
-
可低至10个细胞的实验操作,规避ChIP-seq的大量样本的需求。

图4. ChIP-seq,CUT&Tag,CUT RUN实验流程示意图
翌圣自研ConA磁珠,经过严格的原料筛选、多重工艺的优化和改善,能够快速、高效、灵敏、特异性地与糖蛋白、糖脂、多糖等带有糖基化修饰分子结合。主要用于分离细胞或用于分离细胞或组织裂解液或血清中的糖蛋白等糖基化修饰分子等实验,特别直接用于CUT &RUN和CUT&Tag(ChIP-seq实验的革新性技术)等实验。
-
细胞捕获效率>90%;
-
稳定的批次生产和较好的结果重复性;
-
性能存放稳定。
|
货号 |
Cat#19810ES |
|
规格 |
1mL/5mL/20mL |
|
颜色 |
棕黄色 |
|
磁珠浓度 |
10 mg/mL |
|
固含量 |
9-11 mg/mL |
|
磁珠尺寸大小 |
1 µm |
|
载量 |
105个细胞/μL磁珠 |
|
细胞捕获 |
细胞捕获率>90% |
单分散性
分别取竞品和翌圣ConA磁珠以及翌圣裸球原料各10µL,相同处理条件下,放大倍数10×/40×镜下,翌圣ConA磁珠基本呈单分散性,相对竞品,未见明显团聚。
 |
 |
 |
|
翌圣裸球原料 |
竞品ConA磁珠 |
翌圣ConA磁珠(19810) |
图5. 单分散性结果图
ConA结合细胞效果
相同数量细胞与磁珠结合孵育相同时间,细胞分析仪下自动检测ConA磁珠结合后剩余细胞数量,结果显示翌圣ConA磁珠(Cat#19810)优于竞品。
|
明场 |
|
|
|
|
暗场 |
|
|
|
|
|
待结合细胞悬液 |
经过竞品ConA磁珠结合后剩余的细胞数目 |
经过19810 ConA磁珠结合后剩余的细胞数目 |
图6. ConA磁珠结合细胞结果图
10µL翌圣ConA磁珠(Cat#19810)和10µL竞品ConA磁珠,都可结合E7级别数量的细胞,与竞品相当。重复操作下,细胞捕获率>90%。
|
|
|
图7.ConA磁珠结合细胞数量和捕获率结果图
加速稳定性
按1 mL/管进行分装。储存条件分别为:4℃,37℃加速处理2天、4天、7天、11天和14天,-20℃破坏处理1天、3天、6天和8天。结果显示同等实验条件下:4℃保存产品、37℃加速处理和-20℃破坏处理的产品细胞捕获率>95%,各处理条件下,3组重复CV值在1%以内,重复性良好。
|
|
|
图8. 温度、时间加压下的ConA磁珠细胞捕获率结果和重复性偏差
欢迎大家根据自己的实验需要咨询、选购!
|
产品名称 |
产品编号 |
|
|
CUT&Tag组合套装 |
Hieff NGS® In-Situ DNA Binding Profiling Library Prep Kit for Illumina® V2 |
12597ES |
|
InStab™ Protease Cocktail,EDTA-free,mini,tablet-form 蛋白酶抑制剂Cocktail,EDTA-free,迷你型,片剂 |
20123ES |
|
|
Goat Anti-Mosue lgG(H+L) 山羊抗鼠IgG |
34851ES |
|
|
Hieff NGS® Tagment Index Kit for Illumina® |
12416ES |
|
|
CUT&Tag单品 |
pA-Tn5 Transposase (10 U/μL) |
14528ES |
|
pA-Tn5 Transposase (10 U/μL, without buffer) |
14529ES |
|
|
pG-Tn5 Transposase (10 U/μL) |
14530ES |
|
|
Nanobody-Tn5(anti-mouse & anti-rabbit) |
12595ES |
|
|
Anti-rabbit Tn5 |
12594ES |
|
|
Concanavalin A-Coated Magnetic Beads |
19810ES |
参考文献:
[1].R A Bryce, I H Hillier, J H Naismith, Carbohydrate-protein recognition: molecular dynamics simulations and free energy analysis of oligosaccharide binding to concanavalin A. Biophys J. 81 (Sept. 2001): 1373-88. Abstract. PubMed. Web. 3 Sept. 2010.
[2].Chun-Yang Li, Huai-Long Xu, Bo Liu, Jin-Ku Bao, Concanavalin A, from an Old Protein to Novel Candidate Anti-Neoplastic Drug, Curr Mol Pharmacol. 2010 Nov;3(3):123-8.
[3].Yu-Chen Lee 1, Gregory Block, Huiwen Chen, et al, One-step isolation of plasma membrane proteins using magnetic beads with immobilized concanavalin A, Protein Expr Purif. 2008 Dec;62(2):223-9.
[4].Juanilita T Waniwan, Yi-Ju Chen, Rey Capangpangan, Glycoproteomic Alterations in Drug-resistant Non-small Cell Lung Cancer Cells Revealed by Lectin Magnetic Nanoprobe-based Mass Spectrometry, J Proteome Res. 2018 Nov 2;17(11):3761-3773.
[5].Hatice S Kaya-Okur, Derek H Janssens, Steven Henikoff, Efficient low-cost chromatin profiling with CUT&Tag, Nat Protoc. 2020 Oct;15(10):3264-3283.